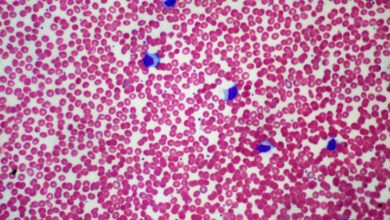

الأمراض
-

مرض السيلياك أو حساسية الغلوتين (Maladie cœliaque)
ما هو الغلوتين (Gluten)؟ الغلوتين هو البروتين الموجود في بعض الحبوب مثل القمح (Blé) والجاودار(Seigle) والشعير(Orge) والشوفان (Avoine) وغيرها. وبالتالي…
أكمل القراءة » -

ما يمكن فعله في حالة الإصابة بداحس الظفر (Panaris)
ما هو داحس الظفر؟ هو التهاب مرضي يتركز على حافة الظفر وعلى المنطقة المحيطة به (سواء كان في اليدين أو القدمين) حيث…
أكمل القراءة » -

الصداع النصفي (الشقيقة)
كيف نتعرف على الصداع النصفي؟ يعتبر الصداع النصفي مرض مزمن يصيب منتصف الرأس يأتي على شكل نوبات متكرّرة من الألم…
أكمل القراءة » -
داء كثرة الوحيدات العدوائية (Mononucléose infectieuse)
ما هو داء كثرة الوحيدات العدوائية؟ داء كثرة الوحيدات العدوائية (Mononucléose infectieuse) أو ما يعرف بداء التقبيل هو مرض فيروسي…
أكمل القراءة » -

تضخم الغدة الدرقية (GOITRE)
ما هو تضخم الغدة الدرقية؟ تضخم الغدة الدرقية (Goitre) يعرف بالزيادة غير الطبيعية في حجمها(Thyroïde). وينتج عنها انتفاخ في المنطقة…
أكمل القراءة » -

التصلّب اللويحي
ما هو مرض التصلب اللويحي (Sclérose en plaque)؟ مرض مزمن يصيب الجهاز العصبي المركزي الذي يتكون من الدماغ والنخاع الشوكي…
أكمل القراءة » -

داء المقوسات (Toxoplasmose)
ما هو داء المقوسات؟ داء المقوسات أو ما يعرف بداء القطط هو واحد من أهم الأمراض الطفيلية المُعدية والمشتركة بين الإنسان…
أكمل القراءة » -

ارتفاع ضغط الدم
ما هو ارتفاع ضغط الدم؟ ارتفاع ضغط الدم هو مرض مزمن يتسبب في ارتفاع ضخ الدم عن معدلاته الطبيعية ليصبح:…
أكمل القراءة » -

الإنفلونزا الموسمية
ما هي الإنفلونزا الموسمية؟ الإنفلونزا الموسمية هي التهاب فيروسي حاد يصيب عادة الأنف والحنجرة والقصبات الهوائية، ويمكن أن يصيب حتى الرئتين.…
أكمل القراءة » -

الحساسية
ما هي الحساسية؟ الحساسية هي ردة فعل مفرطة لجهاز المناعة للجسم (système immunitaire) لمواد غير مألوفة لجسم الإنسان (Allergène)، مثل…
أكمل القراءة »

